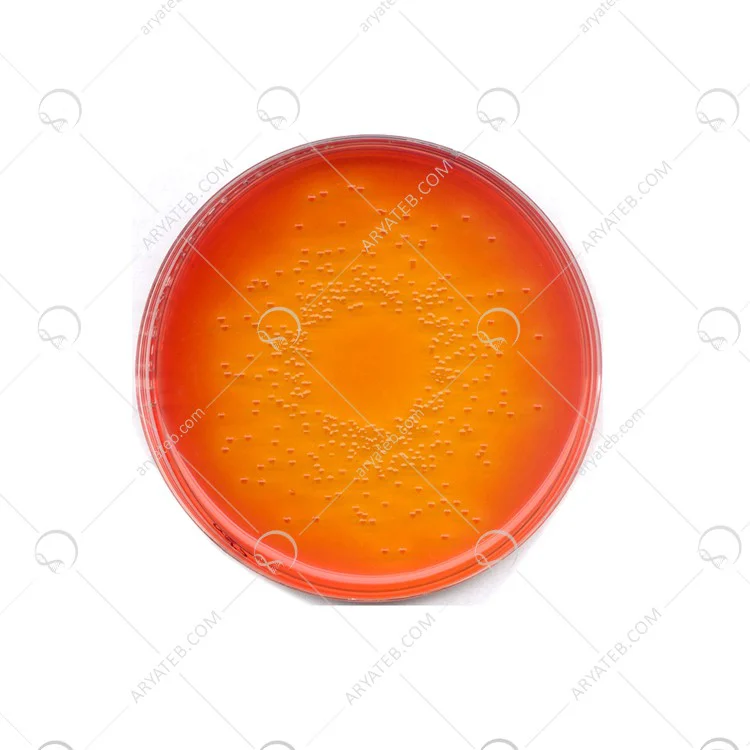

محیط کشت دزوکسی سیترات اگار
محیط کشت Deoxycholate Lactose Agar
محیط کشت Desoxycholat-Lactose-Agar که مخفف محیط کشت DCL Agar می باشد و در زبان فارسی به آن محیط کشت deoxy citrate agar می گویند که یکی دیگر از محیط های فرمولاسیون برای مطالعه و دستیابی به هدف مورد نظر می باشد ، همانگونه که می دانید انواع گوناگونی از محیط کشت ، هر کدام دارای فرمول و ساختار مختلفی می باشند که می توانند برای آزمایش در محیط یکسان استفاده شوند.
محیط کشت DCL Agar
Deoxycholate-Lactose خیلی نزدیک به Deoxycholate Agar کلاسیک است و فقط در میزان Deoxycholate و بعضی تفاوت ها متفاوت است.
با توجه به توصیه های APHA و AOAC ، کاهش ظرفیت بازدارندگی و فرمولاسیون محیطی وجود دارد. مهار میکروارگانیسم های گرم مثبت عمدتا به این علت می باشد که محتوای سدیم دیوکسی کولات ، اگرچه سیترات نیز یک مهار کننده فعال می باشد ، اما باسیل های روده ای ناشی از تخمیر لاکتوز را متمایز می کند. موجوداتی که لاکتوز را تخمیر می کنند در صورت وجود اسید خنثی تولید می کنند
نشانگر قرمز مناطق صورتی ایجاد می کند که این امکان وجود دارد توسط a احاطه شده باشد.
ترکیبات محیط کشت دزوکسی سیترات اگار

دستور العمل تهیه محیط کشت Desoxycholat-Lactose-Agar
- 5.45 گرم پودر دی اکسید سیترات آگار را در 1 لیتر آب مقطر حل کرده و بجوشانید.
- اتوکلاو نکنید و داخل ظروف استریل پتری بریزید. رسانه خود را از دست بدهید
- در صورت گرم شدن بیش از حد کارایی و اجتناب از اتوکلاو یا ذوب مجدد.
Key Spec Table
| ph Value | Solubility |
|---|---|
| 6.9 - 7.3 (57 g/l, H₂O, 25 °C) | 57 g/l |
Pricing & Availability
| Catalogue Number | Availability | Packaging | Qty/Pack | Price | Quantity | |
|---|---|---|---|---|---|---|
| 1028940500 |
— Contact Customer Service |
Plastic bottle | 500 g |
Upon Order Completion More Information |
— |
Add To Cart
| Description | |
|---|---|
| Catalogue Number | 102894 |
| Product Information | |
|---|---|
| HS Code | 3821 00 00 |
| Quality Level | MQ100 |
| Physicochemical Information | |
|---|---|
| pH value | 6.9 - 7.3 (57 g/l, H₂O, 25 °C) |
| Solubility | 57 g/l |
آدرس ایمیل شما منتشر نخواهد شد. فیلدهای الزامی علامت گذاری شده اند *